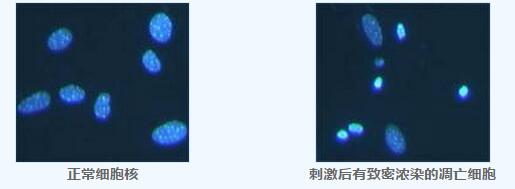
p35/p25抗体北京现货促销

相关产品推荐更多 >
万千商家帮你免费找货
0 人在求购买到急需产品
- 详细信息
- 文献和实验
- 技术资料
- 供应商:
北京百奥莱博科技有限公司
- 库存:
899
- 靶点:
p35/p25
- 目录编号:
YT833
- 克隆性:
多克隆
- 抗原来源:
人
- 保质期:
二年
- 抗体英文名:
anti-p35/p25 antibody
- 抗体名:
p35/p25抗体
- 宿主:
兔
- 适应物种:
人,小鼠,大鼠
- 免疫原:
人工合成的人p35/p25羧基端(carboxy-terminal)的一段多肽
- 形态:
液体
- 应用范围:
WB,IP,IF
- 浓度:
1mg/ml
- 保存条件:
-20℃冻存,避光
特别声明:本产品及我公司所售其他产品均为科研类试剂产品,严禁用于药物、医疗及其他非科研用途。
北京百奥莱博专业生产供应p35/p25抗体北京现货促销,我公司销*(代"售")全品类的抗体抗原,价格优惠,欢迎广大科研工作者垂询订购。
名称:p35/p25抗体北京现货促销
规格:>40次
编号:YT833
英文名:anti-p35/p25 antibody
品牌:百奥莱博
本抗体是用人工合成的人p35/p25羧基端(carboxy-terminal)的一段多肽进行适当修饰后免疫rabbit,然后用protein A和抗原多肽亲和柱经过两步纯化而得到的高纯度抗体。本抗体如果用于常规的Western检测,至少可以检测40次。
本抗体不仅可以识别p35,也同时可以识别p25。
Cdk5(cyclin dependent kinase-5)是细胞周期进程中的一个关键蛋白,在脑中高表达。p35在神经细胞中特异性表达,可以和Cdk5直接结合,并激活Cdk5。p25是p35被calpain剪切后残留下来的羧基端(carboxy-terminal)部分,比p35可以更长时间地激活Cdk5。p25在脑部的累积被认为和老年痴呆症有一定关系。
产品组份:
p35/p25抗体————40μl
Western一抗稀释液————40ml
抗体参数:
免疫原物种:人
免疫原:人工合成的人p35/p25羧基端(carboxy-terminal)的一段多肽
宿主:兔
用途:WB,IP,IF
交叉反应性:人,小鼠,大鼠
抗体识别位点:C-terminal
p35/p25分子量:~25/35kD
推荐稀释比例:WB(1:200-1000),IP(1:50),IF(1:100-500)
注意事项:
1. 在Western实验后,请注意回收稀释的抗体。回收的抗体在进行Western实验时至少可以重复使用10次。稀释后的抗体,包括已经使用过的稀释抗体,4℃保存。
2. 回收后重复使用的抗体,使用方法同新鲜稀释的抗体。如果在重复使用过程中发现抗体出现轻微混浊现象,可以10000g离心1-3分钟,取上清用于后续检测。如果回收的抗体出现明显的絮状物或长霉长菌等情况,则可以考虑废弃该抗体。
3. 对于本抗体,Western检测时一抗要4℃缓慢摇动过夜,如果仅短时间与一抗孵育检测效果较差。
储存条件:-20℃,有效期一年。
更多有关p35/p25抗体北京现货促销的价格及使用说明等,请联*(代"系")我们的业务经理王欣女士咨询,我公司还销*(代"售")以下产品:
·多聚L-赖*酸溶液
编号:YT163
英文名称:Poly-L-lysine Solution
规格:5mg
本产品为已经配制好的Poly-L-lysine溶液,并经过滤除菌处理,可以直接稀释后用于细胞或组织培养方面的实验。分子量大于70,000的多聚赖*酸可以用于促进细胞贴壁生长,本产品可以用于促进细胞的贴壁生长。
CAS:25988-63-0
分子式:L-Lys-(L-Lys)n-L-Lys·xHBr
分子量:150,000~300,000
注意事项:
Poly-L-lysine和Poly-D-lysine都可以用于促进细胞的贴壁生长。Poly-L-lysine可以被某些细胞所消化并吸收,摄入过多的Poly-L-lysine会产生一定的细胞毒性。如果遇到Poly-L-lysine有细胞毒性的情况,可以考虑选购Poly-D-lysine。
储存条件:-20℃。
p35/p25抗体北京现货促销关键词:兔抗人工合成的人p35/p25羧基端(carboxy-terminal)的一段多肽,人工合成的人p35/p25羧基端(carboxy-terminal)的一段多肽抗体,YT833,p35/p25抗体
·卤醇脱卤酶
编号:YT590
英文名称:Halohydrin Dehalogenases (Crude Enzyme)
规格:100ml|1L
本酶为大肠杆菌表达的卤醇脱卤酶,并经简单纯化获得的可以确保达到一定酶活力的粗酶液,可逆性作用于邻羟基卤化物(邻卤醇)形成环氧化物及环氧化物的开环。
CAS:37289-39-7
外观:半透明黄色溶液
酶促反应:(S)-2-haloacid + H2O = (R)-2-hydroxyacid + halide
储存条件:-20℃,有效期1个月。
注意事项:
1. 由于本产品需新鲜制备,在您确认订购后约8个工作日才能发货。
2. 粗酶液的每次冻融均可能会引起部分失活,所以收到酶液后请根据需要进行分装,并置于-20℃或更低温度保存。
3. 随着保存时间的延长,酶活力会有一定程度的下降,收到产品后应尽快使用。
4. 本产品在生产和保存的过程中可能会有混浊或沉淀产生,融化后混匀即可,不影响正常使用。
·细胞凋亡染色试剂盒(细胞Hoechst染色)
编号:YT118
英文名称:Hoechst Staining Kit
规格:100次
本试剂盒提供了一种经典而又快速简便的细胞凋亡检测方法。细胞发生凋亡时,染色质会固缩。所以Hoechst 33258染色后,在荧光显微镜下观察,正常细胞的细胞核呈正常的蓝色,而凋亡细胞的细胞核会呈致密浓染,或呈碎块状致密浓染,颜色有些发白。典型的Hoechst 33258染色后的细胞图片参考下图。
试剂盒特点:
1. 只需25分钟即可完成细胞凋亡检测的整个过程。
2. 本试剂盒提供了固定液,染色液,及抗荧光淬灭封片液。
3. 本试剂盒对贴壁细胞,悬浮细胞和组织切片均适用。
4. 足够检测100个样品。
试剂盒组份:
固定液————————————50ml
Hoechst 33258染色液 —————50ml
抗荧光淬灭封片液 —————— 5ml
注意事项:
1. 需可以观察蓝色荧光的荧光显微镜或激光共聚焦显微镜。
2. 需PBS或0.9%NaCl溶液。
3. 荧光物质均易发生淬灭,染色后的样品宜避光保存。
4. 在使用抗淬灭封片液的情况下可以减缓淬灭,但仍宜尽量避光。
储存条件:4℃,有效期6个月。
p35/p25抗体北京现货促销关键词:兔抗人工合成的人p35/p25羧基端(carboxy-terminal)的一段多肽,人工合成的人p35/p25羧基端(carboxy-terminal)的一段多肽抗体,YT833,p35/p25抗体
SJ0684 100bp
5×MonoClolor蛋白上样液 5×1ml
ARB10881 人抗脊髓灰质炎病毒(PV-Ab)elisa检测 Human anti-poliomyelitis virus antibody ELISA KIT
ARB12431 大鼠骨成型蛋白7(BMP-7)酶联免疫定量检测 Rat bone morphogenetic protein 7,bmp-7 ELISA KIT
9007-34-5 胶原蛋白Ⅰ型 Collagen TypeⅠ
葡萄糖脱*酶 Squalane 9028-53-9
92-32-0 吡啰红G
天青Ⅱ D-Xylulose 37247-10-2
ARB12610 大鼠羟基吲哚一氧一甲基转移酶(HIOMT)ELISA检测服务
ARB11944 大鼠8异前列腺素(8-Iso-PG)血清中含量检测 Rat 8-iso prostaglandin,8-iso-pg ELISA KIT
Weigert弹力纤维染色液 3×50ml
PY02-093 亮绿乳糖胆盐培养基 250克
硫代氧化型辅酶Ⅰ Ethyl stearate 4090-29-3
ARB10436 人甲状腺过氧化物酶(TPO)ELISA代测服务 Human thyroid-peroxidase,tpo ELISA KIT
北京百莱博科技有限公司专业生产供应销*(代"售")生物试剂、化学试剂、抗原抗体、血清血浆、Elisa试剂盒,更多试剂产品需求,欢迎来电咨询选购p35/p25抗体北京现货促销。
风险提示:丁香通仅作为第三方平台,为商家信息发布提供平台空间。用户咨询产品时请注意保护个人信息及财产安全,合理判断,谨慎选购商品,商家和用户对交易行为负责。对于医疗器械类产品,请先查证核实企业经营资质和医疗器械产品注册证情况。
文献和实验祝贺〖雅裕睿安〗成为Signalway Antibody(SAB)独家
祝贺〖上海雅裕 〗成为 Signalway Antibody 品牌 (SAB) 的独家总代理。 促销【 ABCD 】细则如下: 【 A 】 买两支 SAB 抗体免费获得 8G 优盘 活动时间:即日起,至 2011 年
和非组蛋白相关抗体,相关蛋白的修饰化抗体,如甲基化,乙酰化,去乙酰化,磷酸化。抗体价格优惠,性价比高:Western Blot: 1/500 - 1/2000. Immunohistochemistry: 1/100 - 1/300. Immunofluorescence: 1/200 - 1/1000。绝大部分抗体国内现货,及时快捷的为老师提供优质抗体。完善及时的售后服务为老师解决抗体使用的后顾之忧。 ImmunoWay 公司有着自己独特的产品 Cell Based Elisa,适合
外周血是临床检验中的重要标本。FCM分析外周白细胞的主要目的是了解各种白细胞的数目与分群情况。这些数字的变化与临床的某些疾病有一定的关系。近年来,由于多种识别白细胞膜表面抗原的单克隆抗体的发现,以及对这些单克隆抗体的直接或间接荧光标记物的出现,使得利用FCM的荧光组织化学分析获得被测细胞的多指标的更多、更准确的信息,这无疑对警觉临床和科研有很大帮助。本节 主要讨论有关外周血的白细胞的免疫荧光标记技术、数据分析及临床应用等方面的问题。 一、白细胞的免疫荧光标记技术 1.白细胞
技术资料暂无技术资料 索取技术资料










